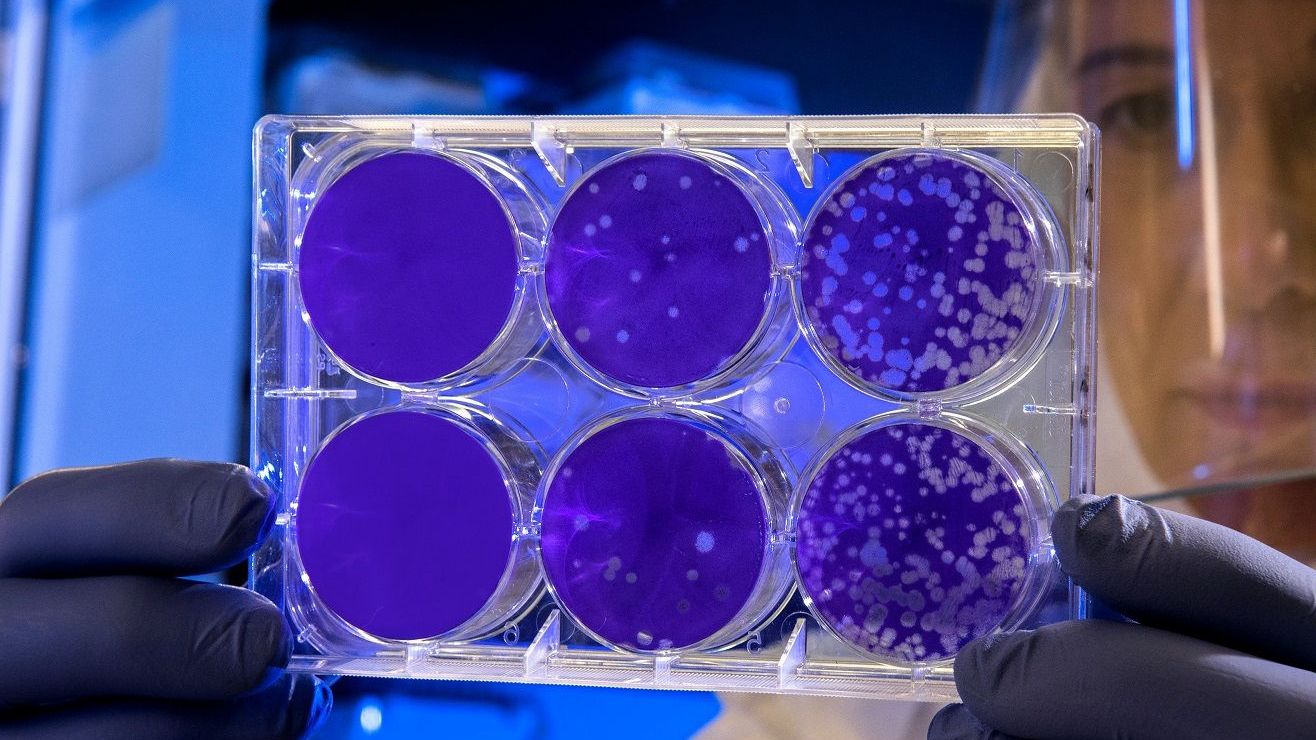

5 datos que debes saber sobre la vacuna contra el coronavirus de AstraZeneca-Oxford que ha logrado resultados positivos
Las primeras pruebas del fármaco son esperanzadoras
Hay unas 150 vacunas en desarrollo en el mundo. Crédito: Unsplash
Alrededor del mundo hay más de 150 vacunas contra el SARS-CoV-2 en desarrollo, pero los ensayos más adelantados se realizan en humanos y ya han comenzado a reportar resultados. Tal es el caso de la vacuna contra el coronavirus de AstraZeneca y la Universidad de Oxford, que ha logrado resultados positivos hasta el momento.
Estos son cinco datos que debes saber sobre este desarrollo científico:
Quiénes
La vacuna experimental fue aplicada a 1,077 voluntarios sanos de entre 18 y 55 años de edad en quienes logró estimular el sistema inmunológico para producir anticuerpos y células blancas (conocidas también como células T) capaces de combatir el virus.
Qué es
Identificado como AZD1222 o ChAdOx1 nCoV-19, el fármaco está producido con base en un virus genéticamente fabricado que ocasiona el resfriado en los chimpancés. Los científicos lo modificaron para hacerlo similar al nuevo coronavirus y lograr así que el sistema inmunológico humano lo reconozca y luche contra él.
Efectos secundarios
Si bien el medicamento logró estimular el sistema inmune de los voluntarios, alrededor del 70 por ciento reportaron fatiga, dolor de cabeza o fiebre no graves que pudieron combatirse con paracetamol.
300 millones para EEUU
La farmacéutica AstraZeneca ha comunicado que su intención no es sacar provecho de su desarrollo durante la pandemia, por lo que ha firmado acuerdos con los gobiernos de todo el orbe para suministrar la vacuna en cuanto demuestre su total efectividad y obtenga las aprobaciones convenientes. En total, su intención es producir más de 2,000 millones de dosis de su vacuna, de las cuales 300 millones estarán destinadas a Estados Unidos.
Su efectividad
Si bien la vacuna produjo resultados positivos para los investigadores, se requieren más ensayos para saber con precisión qué dosis es necesaria para proteger a las personas contra el COVID-19. Inicialmente, los científicos encontraron que la respuesta inmune fue mejor entre los voluntarios que recibieron una segunda dosis del fármaco 28 días después de la primera aplicación.
- 5 cosas que debes saber sobre la primera vacuna contra el coronavirus que se prueba en EEUU
- La inmunidad al coronavirus puede durar sólo unos cuantos meses después de enfermarse
- El medicamento inhalado que reduce el riesgo de COVID-19 grave en 79 por ciento, según sus desarrolladores
- 8 órganos esenciales que el coronavirus puede dañar de manera irremediable





